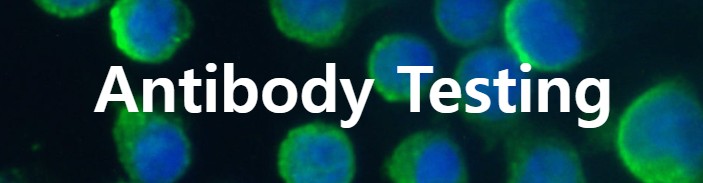

[Shikhar Biotech 한국공식대리점] Antibody Testing Services
As part of our commitment to the advancement of scientific research, we offer a comprehensive range of custom services. Using our special expertise in reproducible, high-quality western blots and fluorescence microscopy, we have been successfully providing antibody-testing services to biotechnology companies based throughout Europe. We currently offer antibody-testing services through Western blotting, ELISA, or Immunofluorescence. Given our flexibility in scaling the testing, no project is too small or too large. If unsure which cells or tissues to use for antibody testing, we will carry out rigorous searches to find the most definitive or putative expression data for your target proteins and shortlist the most suitable cell-lines or tissues to test your antibodies on.
The quality of research antibodies is an ongoing problem for scientists, and issues with specificity, sensitivity and reproducibility are common and can prove costly. With little or no standard validation researchers must rely on reference data when sourcing their reagents as this is the only reassurance that they will perform well in a chosen application.
However, there are challenges with the validation of research antibodies including time and cost constraints, which is where Shikhar Biotech’s custom services can help: Our rigorous antibody validation services enable us to generate good application data for your antibodies, making them more valuable to the scientific community and freeing up your resources so you can focus on your own areas of expertise.
